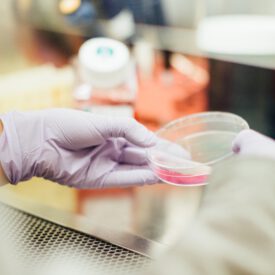

Does your diet keep you awake at night?
Many of you will know that our dietary choices can affect the quality of our sleep. For instance, eating certain foods at night-time (malted milk, bananas) can make it easier to fall asleep, while drinking alcohol can cause sleep interruptions. But did you know that unhealthy diets may also disturb our circadian rhythm? In this blog, I will talk about a recent study with mice that showed how a high-fat diet can disturb their circadian rhythm. A circadian rhythm is a natural, internal process that regulates when we are awake and when we are asleep. The term circadian comes from...
Can short-chain fatty acids lead to a healthy brain? Learn how dietary fiber products in the gut may benefit mental wellbeing.
What are short-chain fatty acids?Non-digestible dietary fibers are fermented in the gut by specific bacteria. During this process, they produce short-chain fatty acids (SCFAs). The most abundant SCFAs are acetate, propionate and butyrate. Acetate is approximately three times more prevalent in the gut compared to propionate and butyrate, though the actual amount depends on the food type, bacterial composition and bowel transit time. What is the major role of SCFAs in maintaining gut health?The most important role of SCFAs is to act as an energy source for gut cells. When there are not enough SCFAs, the gut cannot perform many...
Food Frequency Questionnaire – what is it?
If we want to investigate the effects of diet on mental health and behavior, we need methods to reliably measure a person’s diet. Dietary intake can be measured in several ways; 24-hour recall (dietary intake of the past 24 hours), a food diary (dietary intake is recorded in a diary), or by using a food frequency questionnaire (FFQ). In this blog, I will explain to you more in detail what FFQs are. FFQs are widely used in large scale observational studies as a dietary assessment method. The purpose of FFQs is to obtain frequency and portion size information about food...
COVID19 and the effect on the gut microbiota
Although COVID-19 is primarily a respiratory disease, there is a growing body of evidence showing that it has a direct impact on the gastrointestinal system. Understanding how this system is affected by the disease will help us to better understand its biological mechanisms. Using human cells in petri dishes, researchers from the Netherlands have proven that COVID-19 can infect also gastrointestinal tissue and trigger gut inflammation1. This was later confirmed in living humans, as feces from COVID-19 patients were characterized by elevated levels of the pro-inflammatory marker calprotectin2. Despite this evidence for the strong link between COVID-19 and our gut,...
How has the COVID-19 pandemic influenced our mood?
Throughout this year, we have all felt the effects of the COVID-19 pandemic in one way or another. The pandemic and related measures such as lockdown have been a major part of lives worldwide and have had a wide range of effects, such as isolation, increased stress and fear of contracting or spreading the virus. One further effect that has been present is a change in lifestyle and health behaviours like alcohol consumption, sleep quality, diet and physical activity. As these behaviours have been shown to be linked to mental well-being and differences in mood, a recent study (1) examined...
A coffee a day might keep cognitive decline away
What if enjoying a cup of coffee everyday could preserve your cognitive functioning when aging? In the last decades, the number of individuals that suffer from cognitive decline has increased exponentially. In parallel with an aging population this is a major public health issue. Neurological diseases such as Alzheimer’s disease and other types of dementia have a multifactorial background, which means that they are caused by many different factors, both genetic and environmental. One of these environmental factors is diet, which has a potential beneficial effect on preventing dementia onset and progression. Coffee is one the most consumed beverages worldwide...
Lifestyle psychiatry: how could this benefit people with mental disorders?
Mental disorders affect almost 30% of individuals across the lifespan [1]. There are already a lot of psychotherapies and pharmacological treatments available for these individuals. However, there remains a large proportion of people who do not benefit fully form standard treatment [2,3]. Therefore, new approaches towards the prevention and treatment of mental health problems are needed. These can be delivered alongside traditional mental health care. But what could these new approaches include? Lifestyle factors might be an outcome: an emerging body of research has linked both the onset and symptoms of various mental disorders to lifestyle factors. This term refers...
“We are what we eat” – How diet impacts our brain structure
Food has become omnipresent and plays a huge role in our everyday life. We eat when we’re hungry, as a reward after a successful work day, as a comfort when we are stressed or sad. We also sometimes eat less and exercise more when we want to lose weight. But what many people don’t know – or seem to forget – is that our brain functioning also depends on what we eat. With the research that I did for my master thesis, I found that a healthy diet and regular physical activity are associated with more grey matter in the...
Climbing out of Depression: The Bouldering Psychotherapy
Bouldering is increasingly gaining popularity as a leisure sport as it’s both fun and good physical exercise. But perhaps it can even be used as treatment for depression. A recently published study tested the effects of bouldering therapy on depression and found that ten weeks of bouldering therapy was just as effective in reducing depressive symptoms as the usual treatment, cognitive behavioural therapy. This is an important first step in developing new and effective treatments for depression. The need for new treatments for depressionDepression is one of the most common mental diseases all over the world and its prevalence is...
How low-income parents can reduce their children’s risk of developing problem behavior.
ADHD (Attention-deficit/hyperactivity disorder) is characterized by attention problems and hyperactive and impulsive behaviors. It is one of the most commonly diagnosed conditions in childhood, especially among boys. (1,2) Heritability (genetics) is known to be a main factor in the development of ADHD. However, other risk factors such as gender, diet and socioeconomic status (SES) can strongly influence the development and the course of ADHD in children (you can read more about why ADHD runs in families here). Treatment and management of ADHD include the identification of modifiable risk factors. Some of these risk factors are linked to the consequences of...